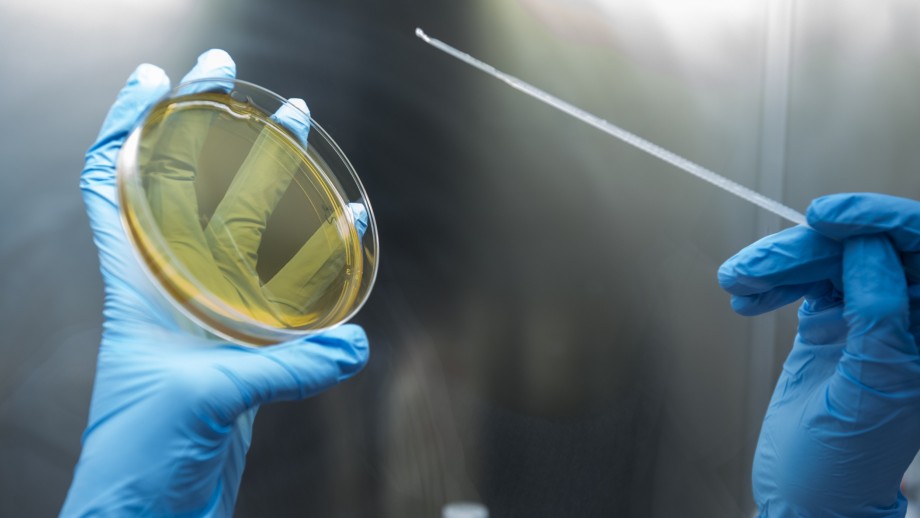

Everything you need to know as a company
We want to be at the forefront of every area where South Tyrol has potential. To keep the world a place worth living in. Where prosperity becomes sustainable, and innovation creates value for people and businesses. In concrete terms, we conduct R&D in four technology sectors: Green, Food & Health, Digital and Automotive/Automation. Hundreds of researchers from all over the world have joined us already. They work with companies and start-ups on R&D projects.
There is an answer: becoming carbon neutral. NOI is part of South Tyrol’s green technology ecosystem. Together we research solutions. Develop marketable products. Test business models. Our companies, start-ups, research institutes and tech transfer professionals work in three core areas: energy systems, sustainable buildings and urban areas, and water technologies.
So much more than food and beverages. We are pioneers in the Food & Health innovation ecosystem. We decode natural processes and ingredients. We recycle by-products. We use biomedical knowledge to develop precision health services. We work with researchers, companies and start-ups on three fronts: raw materials & by-products, optimal processing & fermentation and omics & precision health.
Smooth transportation, safe food, smart homes and machines: data is already providing the basis for intelligent decisions. And in the future, it will be used autonomously and in real-time to make our lives easier. At NOI, we are creating a digital foundation for smart regions. Our researchers, students and tech transfer experts are leading the way in three areas: IoT, Open Data Hub and Artificial Intelligence.
Industrial companies are responsible for the majority of R&D investment in South Tyrol. Leading the way: automotive suppliers. They share a vision of the future in which people complement machines, and machines empower people. In other words: sustainable manufacturing, automotive and mobility solutions. The researchers, students and tech transfer experts work in three areas: Automotive & Mobility, Manufacturing and Agri Automation.